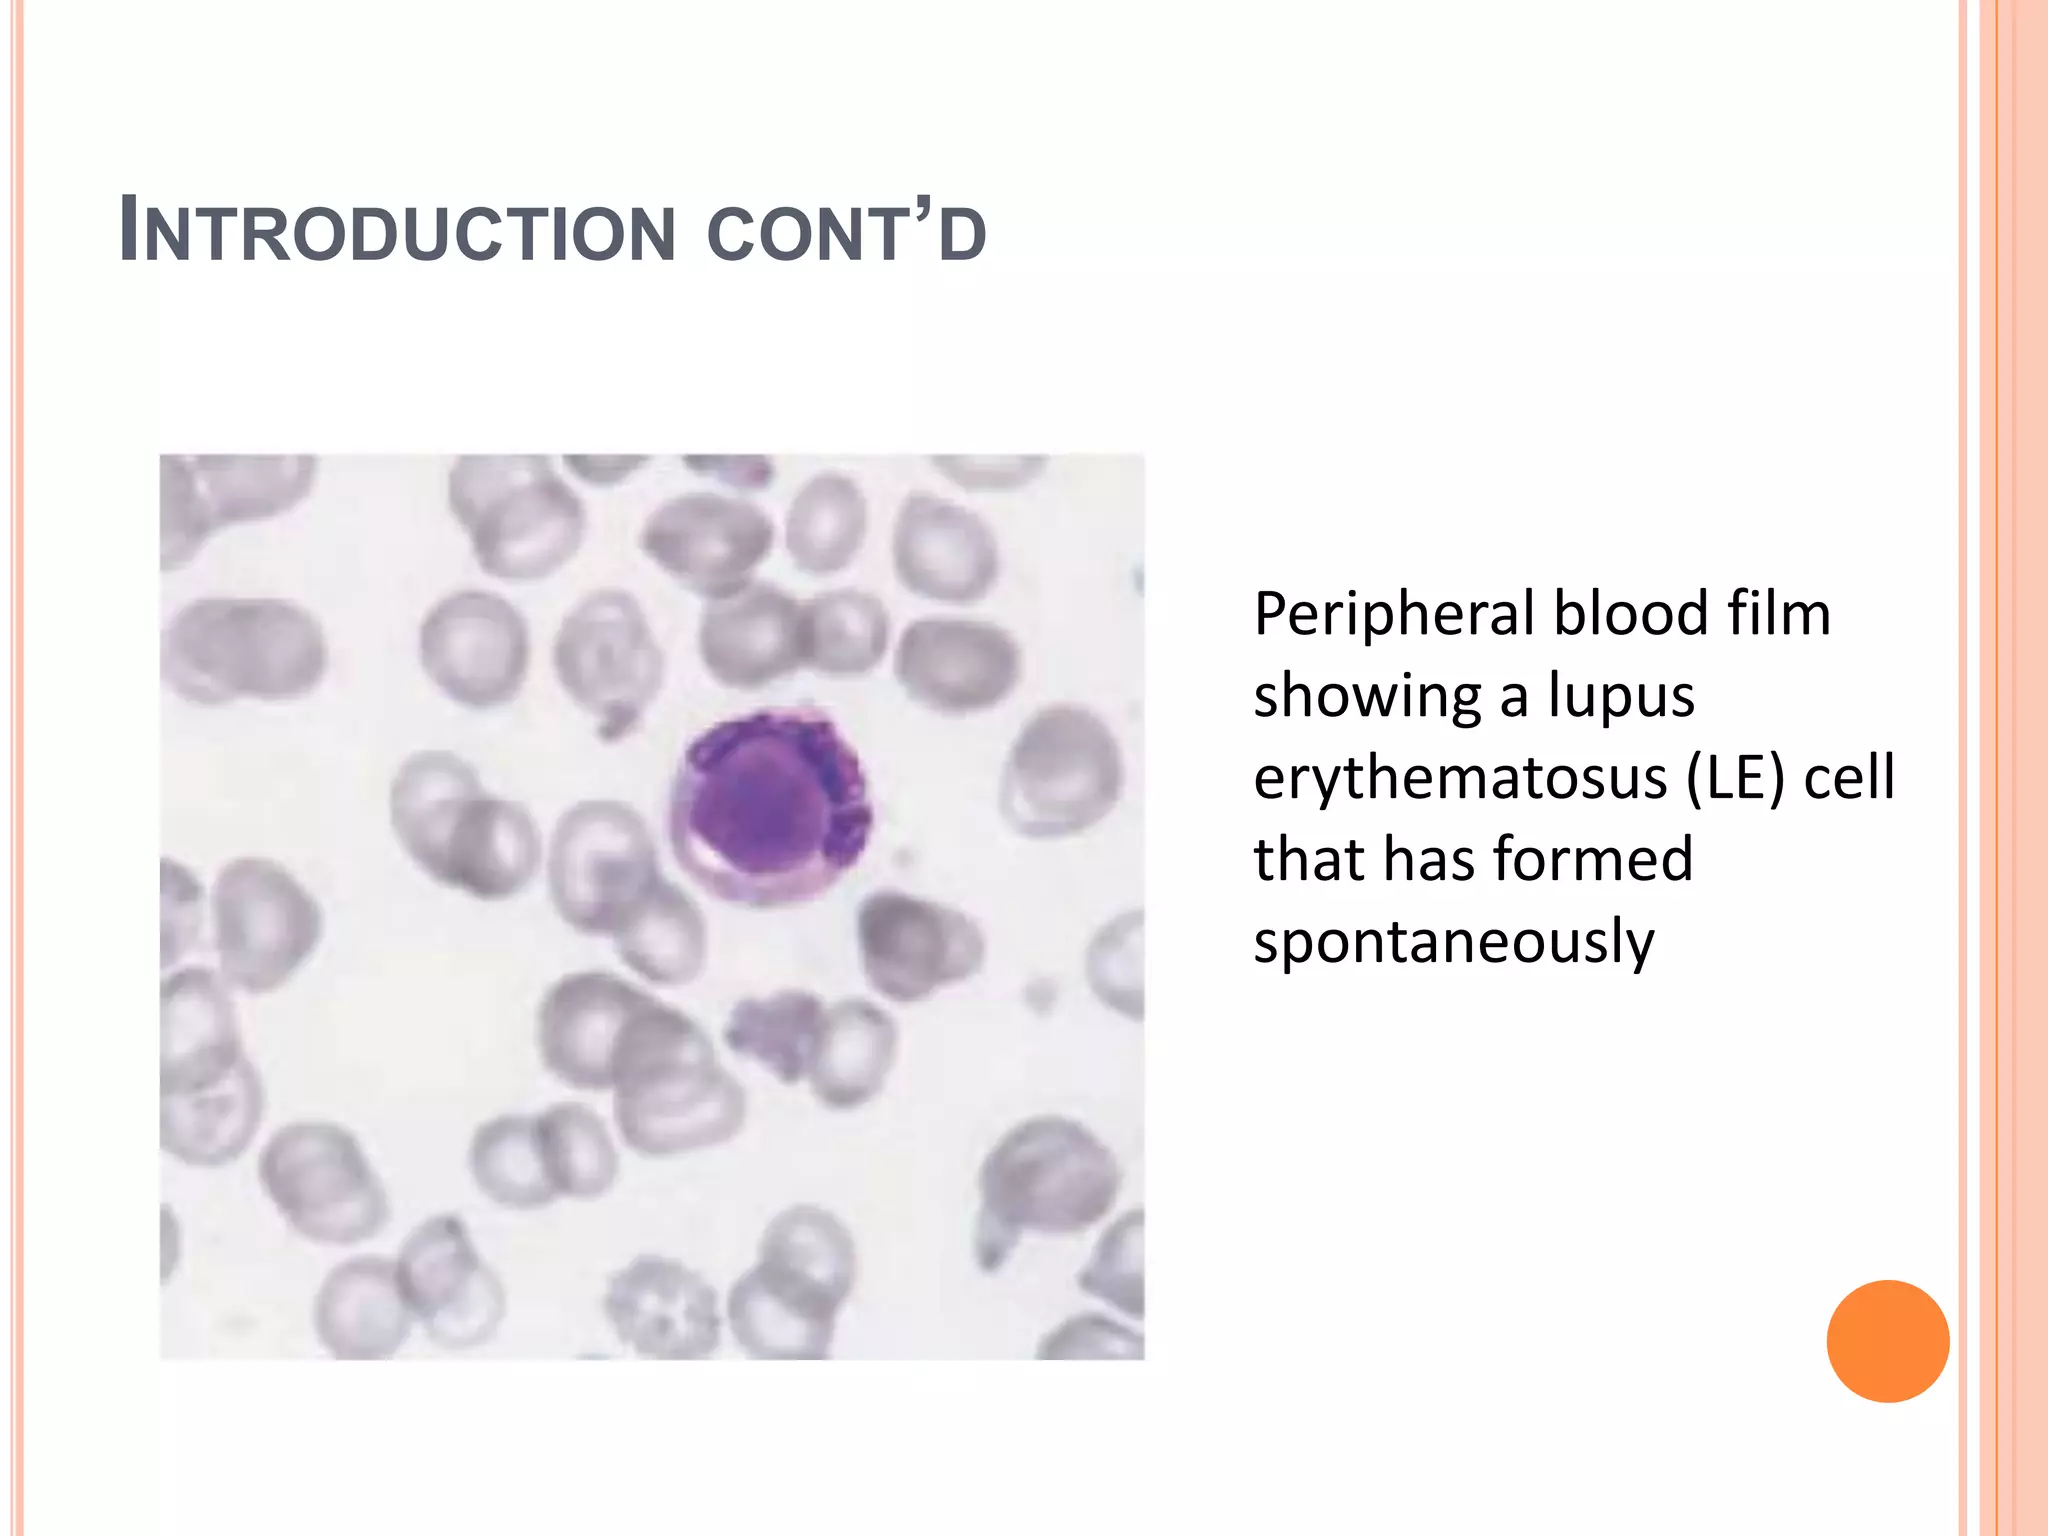
INTRODUCTION CONT’D
Peripheral blood film
showing a lupus
erythematosus (LE) cell
that has formed
spontaneously

This document discusses systemic lupus erythematosus (SLE), a chronic inflammatory disease that can affect many parts of the body including the heart, lungs, skin, joints, blood vessels, and kidneys. SLE is characterized by a rash, fever, renal issues, and abnormalities in blood counts. The disease involves the immune system inappropriately attacking the body's own tissues. A key indicator is the presence of lupus erythematosus cells, which are white blood cells that have ingested pieces of altered nuclear material from other cells. SLE most commonly affects women of childbearing age and those with African ancestry genetics.